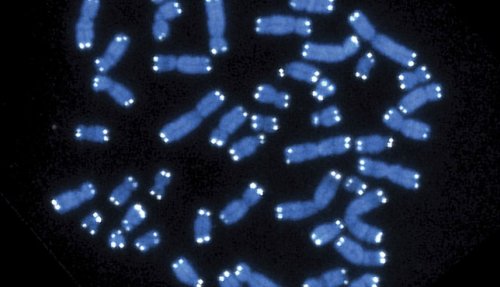

Израильский стартап разработал ИИ-платформу для создания индивидуальной генной терапии - «Технологии»
Фото: Hesed Padilla-Nash, Thomas Ried/National Cancer Institute/National Institutes of Health via AP
Компания Cassidy Bio разработала систему искусственного интеллекта, которая позволяет на порядок ускорить создание индивидуальной генной терапии для пациентов.
Израильская биотехнологическая компания Cassidy Bio представила платформу для проектирования генной терапии на основе редактирования генома. Основой системы является ИИ-модель, которая объединяет данные собственных лабораторных экспериментов компании, информацию о геномах десятков тысяч людей и методы машинного обучения. Модель предсказывает оптимальные комбинации направляющих молекул, ферментов-редакторов и способов доставки для конкретных терапевтических задач.
Традиционный подход к созданию генной терапии часто требует многолетних экспериментов. Каждый компонент системы редактирования – направляющая РНК, фермент и механизм доставки – разрабатывается отдельно, что замедляет процесс и увеличивает риски. Платформа Cassidy Bio делает этот процесс более предсказуемым, позволяя проверять безопасность и эффективность биоконструкций на цифровой модели еще до начала экспериментов.
Главное преимущество системы – способность учитывать огромное генетическое разнообразие разных людей. Модель обучена на 70 тысячах геномов, что позволяет оценивать, как терапия будет работать у людей с разными генетическими вариантами. Система также предсказывает возможные побочные эффекты редактирования – одну из главных проблем безопасности генной терапии.
Компания утверждает, что разработанный подход сокращает время разработки с нескольких лет до нескольких недель. Результаты лабораторных экспериментов постоянно поступают обратно в систему, улучшая точность предсказаний. Это создает замкнутый цикл между вычислительной моделью и биологическими данными.
Cassidy Bio привлекла $8 миллионов посевного финансирования.
newsru.co.il
Похожие новости
Похожие новости